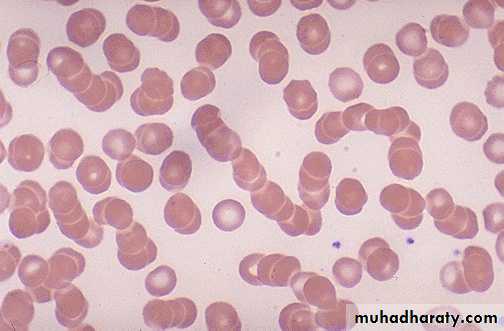

Erythrocyte sedimentation rate (ESR)
Introduction and principle:When blood, mixed with anticoagulant, is allowed to stand in a special, narrow vertical tube, for a period, RBCs settle down (sediment) leaving clear plasma above.
ESR is the rate at which RBCs sediment. It is measured by the distance that the RBCs have settled down, in millimeters, in a given period, which is usually one hour.
Rouleaux formation…RBCs arranged one on the top of the other…..the surface area is reduced, and the weight is increased, leading to increased rapidity of sedimentation.
Pro-sedimentation factors, mainly fibrinogen and globulins
Factors resisting sedimentation, namely the negative charge of the erythrocytes(albumin)
The balance between above factors governs the ESR.
Therefore, the factors that increase rouleaux formation increase the ESR, and those factors that decrease rouleaux formation decrease the ESR.
Factors which affect ESR
1. Plasma proteinsIncreased concentrations of fibrinogen or globulin & acute phase proteins (increased in acute inflammationor tissue injury)…….all increase aggregating ability, therefpore, increase rouleaux formation and increase ESR.
Increased concentrations of albumin in plasma increase RBC negative charge so reduce rouleaux formation and decrease ESR.
2. Concentration of RBCs: Increased RBC concentration or high Hct increases the viscosity of blood thus increasing the resistance to sedimentation, which leads to decrease in ESR and vice versa.
Viscosity is important in circulatory function because it partially governs the flow of blood through the vessels.
Increased viscosity…..increased resistance….decrease blood flow and vice versa.
Either of these conditions puts a strain on the heart that may lead to serious cardiovascular problems if not corrected.
3. Shape of RBCs: RBCs with abnormal or irregular shapes such as sickle cells or spherocytes interfere with rouleaux formation leading to decreased ESR.
ESR is not a specific test so it doesn’t give an indication about the type or site of disease but it's used for the follow up of the patient and the prognosis of the condition.
Affected by other conditions besides inflammation thus used in conjunction with other tests.
In people above 60 years of age, higher values are not necessarily abnormal.
ESR method, material and instruments
Westergren pipette it is glass tube (30 cm in length & 2.55 mm in width), opened at both ends & graduated from 0-200 mm.Westergren pipette rack equipped with leveling screws
3.8% Sodium citrate as an anticoagulant in a ratio of 1:4 with bloodSyringe for the withdrawal of blood from the vein of the patient.
Procedure:-Withdraw 2 cc of blood from the patient’s vein using the syringe.
Put 0.4 cc of sodium citrate in a plain test tube.
Immediately add 1.6 ml blood from the syringe to the plain tube making a dilution of 1:4 ratio and shake it for mixing.
Fill the Westergren pipette to exactly the 0 mark making certain that there are no air bubbles at all in the blood
Place the pipette vertically on the rack and leave it to stand still undisturbed for one hour.
At the end of the 60 minutes read the no. of millimeters the RBC's have fallen (i.e. the height of clear plasma above the upper limit of the column of sedimentary cells) the result is the ESR in mm/ in 1 hour.
Technical errors
A tilted ESR tube.
Increase temperature.
Sample dilution.
Inadequate anticoagulation with clotting of the blood sample (consequently will consume fibrinogen)…………result will?
Medical application
The ESR increase in:Physiological
pregnancy, menstruation & parturition
Pathological
anemia, infections, malignancy, and inflammation.
The ESR decrease in:
polycythemia, spherocytosis, and sickle cell anemia.